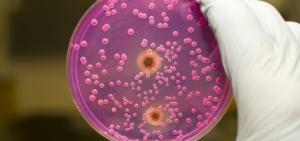

Исследование микоплазмы и уреаплазмы
Исследование на микоплазму и уреаплазму – обязательная часть обследования на венерические болезни.
Проводить исследование на микоплазмы следует регулярно проводить каждому сексуально активному человеку.
Микоплазмы и уреаплазмы относятся к условно-патогенным микроорганизмам.
При нормальном уровне иммунитета и здоровой микрофлоре они не вызывают болезни.
Если происходит ослабление организма, микроорганизмы начинают бурно размножаться.
Это становится причиной развития таких заболеваний, как микоплазмоз и уреаплазмоз.
Когда надо проходить исследование на микоплазму и уреаплазму?
Исследование на микоплазму и уреаплазму проводят в следующих случаях:
- 1.Воспалительные болезни мочеполовой системы;
- 2.Наличие уреаплазмы или микоплазмы у сексуального партнера;
- 3.Случайный незащищенный сексуальный контакт;
- 4.Планирование беременности;
- 5.Бесплодие;
- 6.Выкидыши и мертворождение;
- 7.Наличие венерических болезней.
Если вы проходите регулярное обследование, не забудьте проверится и на эти микроорганизмы.

О том как проходит исследование
микоплазмы и уреаплазмы
рассказывает подполковник
медицинской службы, врач
Ленкин Сергей Геннадьевич
Содержание данной статьи проверено и подтверждено на соответствие медицинским
стандартам врачем дерматовенерологом, урологом, к.м.н.
Ленкиным Сергеем Геннадьевичем
Наименование | Срок | Цена |
---|---|---|
ДНК Mycoplasma hominis | 1 д. | 300.00 руб. |
ДНК Mycoplasma genitalium | 1 д. | 300.00 руб. |
ДНК Ureaplasma urealyticum | 1 д. | 300.00 руб. |
Посев на Mycoplasma hominis и Ureaplasma species с определением чувствительности к антибиотикам | 5 д. | 1500.00 руб. |
Исследование на микоплазму и уреаплазму: методы
Для диагностирования микоплазмы и уреаплазмы наиболее часто используют следующие лабораторные анализы:
- Культуральные посевы;
- ПЦР ;
Раньше для поиска микоплазмы и уреаплазмы использовался ИФА.
Сейчас метод не применяется, поскольку является неточным и часто дает ложные результаты.
Микробиологическое исследование на микоплазму и уреаплазму дает возможность определить:
- Отсутствие или наличие возбудителя;
- Его количество;
- Восприимчивость к препаратам.
Метод дает представление, необходима ли терапия и какие лекарства наиболее эффективны.
Материалом является соскоб слизистой мочеиспускательного канала, шейки матки и влагалища.
Важно! При подготовке к анализу, нельзя мочиться за 2-3 часа до исследования.
Женщинам лучше проводить исследование за 3 дня до менструаций или спустя 3 дня после их завершения.
Микробиологическое исследование на микоплазму и уреаплазму, посев, не выявляет микоплазму гинеталеум.
Для обнаружения этого организма используется метод ПЦР.
Анализ ПЦР – эффективный метод обнаружения микоплазм и уреаплазм.
Такое исследование обнаруживает свойственные только этим организмам фрагменты ДНК.
Для анализа берут венозную кровь или соскоб со слизистых.
Если проводится исследование соскоба методом ПЦР, микоплазма обнаруживается более точно.
ПЦР в нашей лаборатории дает возможность обнаружить микроорганизмы и узнать их количественный показатель.
Это отличает его от стандартного ПЦР, которое может только выявить наличие возбудителя.
Исследование на микоплазму и уреаплазму: расшифровка анализов
Метод ПЦР предусматривает два вида результата: положительный и отрицательный.
Отрицательный результат указывает на то, что возбудителя нет.
Положительный анализ свидетельствует о присутствии микоплазмы или уреаплазмы.
Культуральный микробиологический анализ показывает наличие микроорганизмов и их количество.
Если концентрация возбудителей составляет не больше 10 в 4 степени колоний на 1 мл, это означает носительство.
При таком содержании микоплазмы и уреаплазмы не вызывают заболевания и не требуют лечения.
Превышение этих показателей свидетельствует о заболевании.
Помните! Результат анализа не является диагнозом!
Для расшифровки результата анализов на микоплазму или уреаплазму проконсультируйтесь с врачом!
Сдать анализы можно в нашей клинике, обращайтесь, работаем без выходных.

Провести диагностику и лечение ВЫ можете в нашей клинике, где есть все необходимое оборудование, а прием ведет опытный гинеколог, врач высшей категории
8 (495) 916-13-86
с 9:00 до 21:00

Провести диагностику и лечение ВЫ можете в нашей клинике, где есть все необходимое оборудование, а прием ведет опытный врач венеролог, уролог, врач высшей категории, кандидат медицинских наук
8 (495) 916-13-86
с 9:00 до 21:00

Провести диагностику и лечение ВЫ можете в нашей клинике, где есть все необходимое оборудование, а прием ведет опытный врач венеролог, уролог, врач высшей категории, кандидат медицинских наук
8 (495) 916-13-86
с 9:00 до 21:00